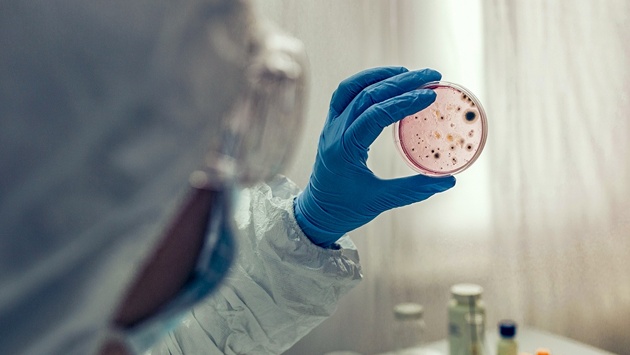

Профессор Никифоров оценил риски появления холеры в РФ после вспышки на Украине
Сегодня стало известно о вспышке холеры в Херсонской области. О возможных причинах распространения инфекции и о том, велик ли риск, что холера появится и в России, рассказал заслуженный врач России, заведующий кафедрой инфекционных болезней и эпидемиологии лечебного факультета РНИМУ им. Н.И. Пирогова Владимир Никифоров.
Как передается холера?
Холера - это типичная банальная кишечная инфекция, то есть передается исключительно фекально-оральным путем. Возбудитель находится в продуктах жизнедеятельности больного. Грубо говоря, если частицы кала больного холерой попадут на продукты питания или в питьевую воду, - тот, кто это съест и выпьет, - заразится. Именно это и есть фекально-оральный механизм заражения.
Путь передачи для холеры - как правило, водный. Холерный вибрион абсолютно не выдерживает высыхания. Поэтому он живет и размножается только в какой-то влажной среде или воде. И в организм попадает, как правило, с питьем воды. Контактно-бытовой путь передачи крайне редок. Он тоже возможен, но он не является главным.
Источником заражения является только человек, возбудитель передается только от больного человека к здоровому. Носительство при форме холера Эль-Тор, которая сейчас главенствует, возможно в течение полугода, не более. Хронического носительства, как, например, при брюшном тифе, когда здоровый внешне человек выделяет патоген и может заражать других, такого при холере нет.
Каковы симптомы холеры?
Основные симптомы - понос и рвота. Причем сначала начинается понос, потом возникает рвота, а когда человек начинает выздоравливать, сначала прекращается рвота, потом понос.
Холера вызывает ужасающий понос и рвоту - из-за потери большого количества жидкости наступает обезвоживание, и это может быть смертельно опасно. С поносом и рвотой человек может потерять не более 10% массы тела - если их вовремя не остановить, могут наступить фатальные последствия. Грубо говоря, если 60-килограммовый человек потеряет 6 литров на рвоту и понос, то это для него уже смертельно, если не компенсировать эти потери. Но при холере этот объем потерять достаточно легко, и именно этим она особенно опасна.
Почему холера так страшна?
"В современных условиях, с нашим уровнем знаний при холере умирать не от чего, потому что мы можем полностью компенсировать потери жидкости. Сколько человек теряет, столько мы будем вливать ему в вену обратно. Но если не будем компенсировать, больной быстро умрет. На моем веку одному больному за три дня ввели 158 литров жидкости. А потерять без компенсации можно не более 10% массы тела", - рассказал профессор Никифоров.
Главная угроза в том, что в медучреждение больные поступают иногда поздно, а если вспышка крупная и будет массовое поступление заболевших, то у медиков просто может не хватить запаса необходимых лекарств и инфузионных растворов.
Возможно ли, что холера придет в Россию из Украины?
Исключить такие риски нельзя, если есть общие водные пути - например, если река протекает по обеим территориям. Поэтому сейчас необходимо особенно строго соблюдать меры предосторожности: нельзя пить воду ни из каких неясных источников. Можно пить только проверенную воду, кипяченую или бутилированную. И, конечно, нужно соблюдать правила личной гигиены.